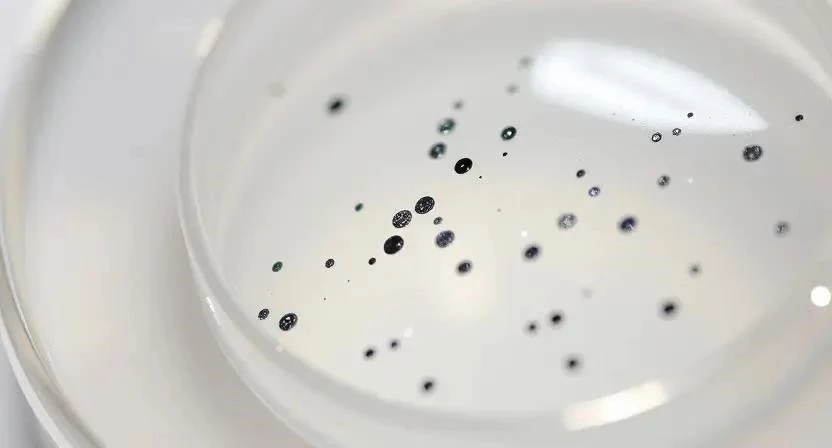

Хотите создать незабываемый образ на Хэллоуин? Мечтаете о жутко красивом и при этом эффектном макияже? Блестки для тела – это отличный способ преобразиться и стать центром внимания на любой тематической вечеринке. Использование блесток для создания образа паука – это настоящий тренд последних лет, позволяющий добиться потрясающего мерцающего эффекта. В этой статье мы расскажем, как выбрать качественные блестки, подготовить кожу, создать эффект паутины и дополнить образ другими элементами макияжа.
Что такое блестки для тела
Блестки для тела – это декоративная косметика, предназначенная для создания мерцающего эффекта на коже. Они могут быть разных видов, размеров, цветов и форм. Состав блесток может варьироваться: от натуральных минеральных частиц до синтетических полимеров. Важно выбирать качественные блестки, которые не вызывают раздражения и легко смываются. Безопасность – ключевой фактор при выборе блесток. Обратите внимание на состав: предпочтительнее выбирать блестки на основе натуральных компонентов, без содержания микропластика. Качественные блестки должны быть гипоаллергенными и протестированными дерматологами.
Виды блесток:
- Глиттер: Крупные блестки, создающие яркий и заметный эффект.
- Мелкие блестки: Идеальны для деликатного мерцания и создания эффекта «сахарной пудры».
- Голографические блестки: Меняют цвет в зависимости от угла освещения, создавая потрясающий эффект.
- Перламутровые блестки: Обладают нежным сиянием и подходят для создания романтичного образа.
- Флуоресцентные блестки: Светится в ультрафиолетовом свете, идеально для вечеринок.
- Биоразлагаемые блестки: Экологически чистый вариант, не наносит вреда окружающей среде.
- Блестки в геле: Удобны в нанесении и не осыпаются.
Таблица: Виды блесток и их характеристики
| Вид блесток | Размер | Эффект | Применение | Цена (руб.) |
|---|---|---|---|---|
| Глиттер | Крупный | Яркий, заметный | Хэллоуин, вечеринки | 300-800 |
| Мелкие блестки | Мелкий | Деликатное мерцание | Повседневный макияж | 200-500 |
| Голографические | Средний | Изменение цвета | Креативный макияж | 500-1200 |
| Перламутровые | Мелкий | Нежное сияние | Романтичный образ | 250-600 |
| Флуоресцентные | Средний | Свечение в УФ | Вечеринки в клубе | 400-900 |
Подготовка кожи
Чтобы блестки хорошо держались и не вызывали раздражения, необходимо правильно подготовить кожу. Начните с тщательного очищения кожи с помощью мягкого геля или пенки для умывания. После очищения нанесите увлажняющий крем, подходящий вашему типу кожи. Затем используйте праймер для лица, который создаст ровную поверхность и улучшит сцепление блесток с кожей. Я всегда использую увлажняющий тоник после умывания, чтобы восстановить pH-баланс кожи. Это помогает избежать раздражения после нанесения блесток.
- Очищение кожи мягким средством.
- Увлажнение кожи кремом.
- Нанесение праймера для лица.
- Тщательное высушивание кожи.
- Тест на аллергию (нанесите небольшое количество блесток на небольшой участок кожи).
- Использование бальзама для губ, если планируется нанесение блесток на губы.
- Избегайте нанесения блесток на поврежденную кожу.
Как создать эффект паутины
Создание эффекта паутины с помощью блесток – это увлекательный процесс, требующий немного терпения и аккуратности. Используйте трафареты с изображением паутины, чтобы получить четкий и ровный рисунок. Если у вас нет трафаретов, можно нарисовать паутину вручную с помощью тонкой кисти и клея для тела. Наносите блестки на клей с помощью кисти или спонжа. Я помню, как в первый раз пыталась нарисовать паутину вручную – это оказалось довольно сложно, но результат того стоил! Главное – не торопиться и аккуратно прорисовывать каждую линию.
Пошаговая инструкция:
- Нанесите клей для тела на кожу в форме паутины.
- Посыпьте клей блестками, используя кисть или спонж.
- Аккуратно удалите излишки блесток.
- Зафиксируйте результат с помощью лака для волос (опционально).
- Дополните образ другими элементами макияжа.
- Повторите процедуру для создания более плотной паутины.
- Используйте разные оттенки блесток для создания объема.
Таблица: Пошаговая инструкция нанесения паутины
| Этап | Действие | Инструмент | Время |
|---|---|---|---|
| 1 | Нанесение клея для тела | Тонкая кисть | 5-10 минут |
| 2 | Посыпка блестками | Кисть или спонж | 3-5 минут |
| 3 | Удаление излишков | Мягкая кисть | 2-3 минуты |
| 4 | Фиксация лаком | Лак для волос | 1 минута |
Техники нанесения блесток
Существует несколько техник нанесения блесток, каждая из которых имеет свои преимущества и недостатки. Сухое нанесение – самый простой способ, при котором блестки наносятся непосредственно на кожу с помощью кисти. Влажное нанесение позволяет добиться более интенсивного блеска, но требует использования клея для тела. Использование клея для тела обеспечивает максимальную фиксацию блесток и позволяет создавать сложные рисунки. Я предпочитаю влажное нанесение, так как блестки держатся дольше и выглядят ярче.
- Сухое нанесение: Просто и быстро, но блестки могут осыпаться.
- Влажное нанесение: Более интенсивный блеск, но требует использования клея.
- Использование клея для тела: Максимальная фиксация и возможность создания сложных рисунков.
- Нанесение с помощью спонжа: Равномерное покрытие.
- Нанесение с помощью кисти: Точное нанесение и создание акцентов.
- Использование трафаретов: Создание четких рисунков.
- Многослойное нанесение: Усиление эффекта.

Цветовая палитра
Для образа паука лучше всего подходят темные и насыщенные цвета блесток. Черный цвет символизирует таинственность и опасность, серебристый – мерцание паутины, фиолетовый – мистику и загадочность. Можно использовать комбинацию этих цветов для создания более интересного и эффектного образа. Я однажды использовала темно-синие блестки для создания образа паука, и это выглядело очень необычно и стильно.
Таблица: Цветовая палитра для образа паука
| Цвет | С чем носить | Эффект |
|---|---|---|
| Черный | Серебристый, фиолетовый | Таинственность, опасность |
| Серебристый | Черный, фиолетовый | Мерцание, элегантность |
| Фиолетовый | Черный, серебристый | Мистика, загадочность |
Дополнительные элементы макияжа
Чтобы образ паука был более завершенным, дополните его другими элементами макияжа. Используйте темные тени для век, чтобы создать эффект «смоки айс». Нарисуйте тонкие стрелки подводкой, чтобы подчеркнуть глаза. Нанесите темную помаду на губы, чтобы придать образу драматичности. Я всегда использую контуринг, чтобы подчеркнуть скулы и сделать лицо более выразительным.
Безопасность
При использовании блесток важно соблюдать меры предосторожности, чтобы избежать раздражения кожи. Перед использованием блесток проведите тест на аллергию на небольшом участке кожи. Не наносите блестки на поврежденную кожу. Чтобы правильно смыть блестки, используйте мягкое средство для снятия макияжа и теплую воду. Я всегда использую мицеллярную воду для снятия блесток, так как она эффективно удаляет даже самые стойкие блестки.
Идеи образов
Существует множество вариантов макияжа паука с использованием блесток. Можно создать классический образ с черной паутиной на лице, или более креативный образ с использованием разных цветов и техник нанесения. Я однажды создала образ паука с использованием фиолетовых и серебристых блесток, и это выглядело очень эффектно и необычно.
Советы экспертов
Визажисты рекомендуют использовать качественные блестки и правильно подготовить кожу перед нанесением. Не бойтесь экспериментировать с разными цветами и техниками нанесения. Главное – проявить фантазию и создать уникальный образ, который подчеркнет вашу индивидуальность.
FAQ
Вопрос: Какие блестки лучше всего подходят для образа паука?
Ответ: Черные, серебристые и фиолетовые блестки.
Вопрос: Как правильно смыть блестки?
Ответ: Используйте мягкое средство для снятия макияжа и теплую воду.
Вопрос: Можно ли использовать блестки на чувствительной коже?
Ответ: Да, но перед использованием проведите тест на аллергию.
